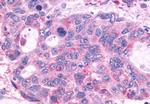
GPR150 Antibody in Immunohistochemistry (Paraffin) (IHC (P))

Search
Invitrogen
GPR150 Polyclonal Antibody
{{$productOrderCtrl.translations['antibody.pdp.commerceCard.promotion.promotions']}}
{{$productOrderCtrl.translations['antibody.pdp.commerceCard.promotion.viewpromo']}}
{{$productOrderCtrl.translations['antibody.pdp.commerceCard.promotion.promocode']}}: {{promo.promoCode}} {{promo.promoTitle}} {{promo.promoDescription}}. {{$productOrderCtrl.translations['antibody.pdp.commerceCard.promotion.learnmore']}}

Please note: We are reviewing Western blot images included in the antibody testing data in our catalog, including those provided by third parties. Unless expressly labeled or annotated as “raw-unedited”, Western blot images included in the antibody testing data in our catalog may have been edited, optimized or otherwise adjusted for presentation.
产品信息
PA5-33645
种属反应
宿主/亚型
分类
类型
抗原
偶联物
形式
浓度
规格
纯化类型
保存液
内含物
保存条件
运输条件
RRID
产品详细信息
Percent identity with other species by BLAST analysis: Human, Gorilla (100%) Monkey (94%).
靶标信息
G protein-coupled receptors (GPCRs), also designated seven transmembrane (7TM) receptors and heptahelical receptors, are a protein family which interact with G proteins (heterotrimeric GTPases) to synthesize intracellular second messengers such as diacylglycerol, cyclic AMP, inositol phosphates, and calcium ions. Their diverse biological functions range from vision and olfaction to neuronal and endocrine signaling and are involved in many pathological conditions. G protein receptor 150 (GPR150), also designated PGR11 and seven transmembrane helix receptor, is a member of the rhodopsin family of GCPRs and is involved in signal transduction. GPR150 is expressed in various human tissues, including normal small intestine, skeletal muscle, kidney and tonsil, as well as cancerous blood, bladder, placenta and parathyroid.
仅用于科研。不用于诊断过程。未经明确授权不得转售。




